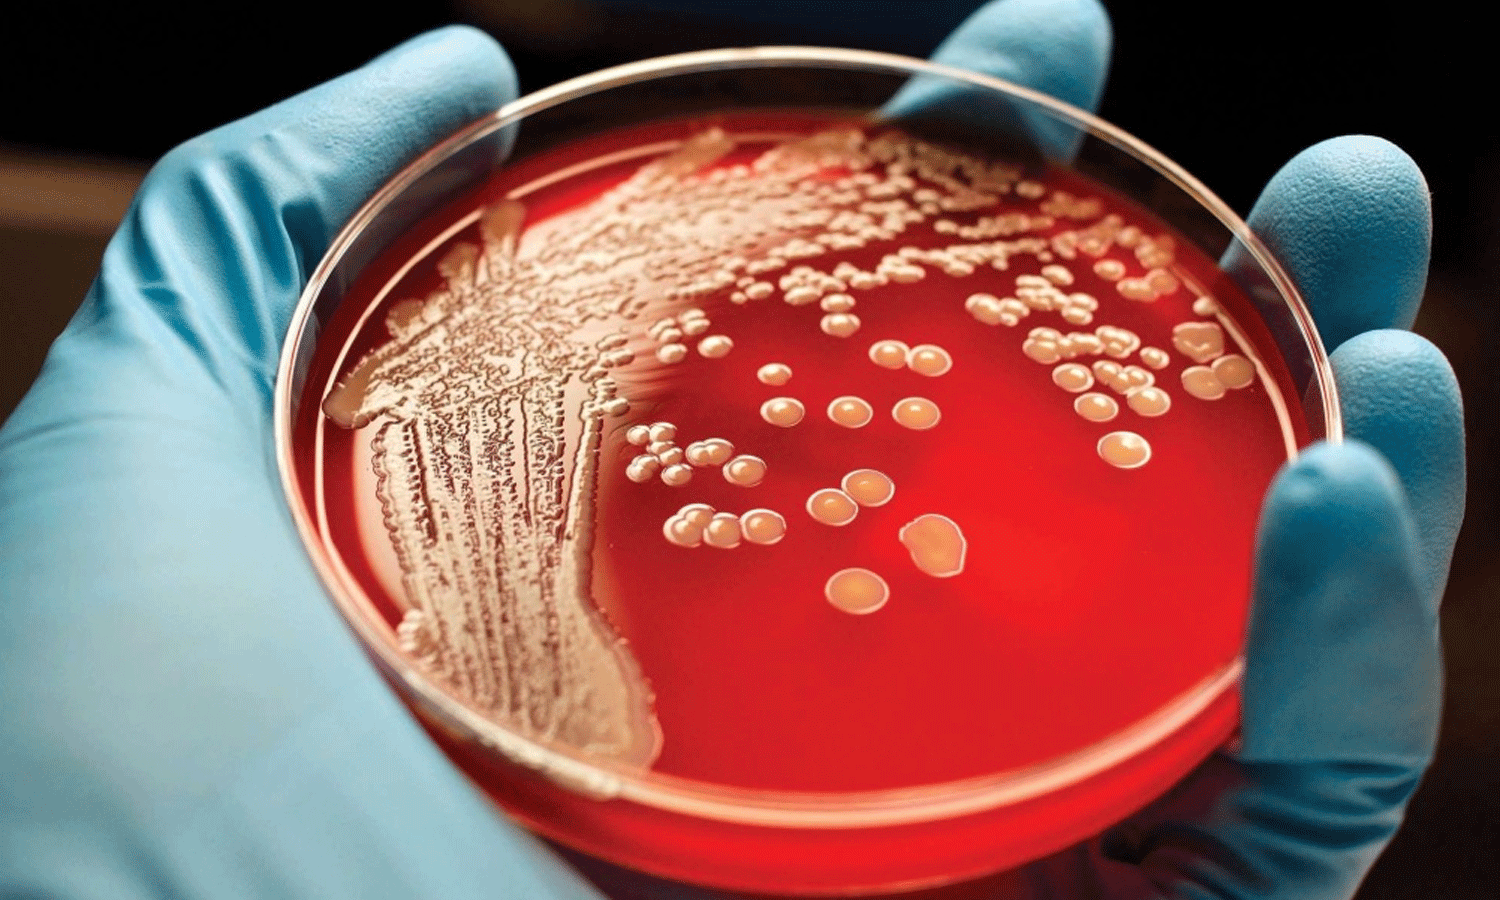

രക്താർബുദത്തെ നേരത്തെ അറിയാം; പ്രധാന ലക്ഷണങ്ങള്
|ശരീരം നൽകുന്ന ചെറിയ ചില മുന്നറിയിപ്പുകളെ അവഗണിക്കാതിരുന്നാൽ ആർക്കും രക്താർബുദം തുടക്കത്തിലേ തിരിച്ചറിയാനാകും
അർബുദം ആഗോളതലത്തിൽ പ്രതിദിനം വർധിച്ചുവരുന്ന അവസ്ഥ നിലവിലുണ്ട്. പ്രായഭേദമന്യേ ആർക്കും പിടിപെടാവുന്ന രോഗമാണിത്. അർബുദത്തേക്കാള് ആളുകളിൽ ഭീതിപടർത്തുന്ന ഒന്നാണ് രക്താർബുദം. അർബുദത്തിന്റെ ചികിത്സയോളം പ്രാധാന്യം എത്രത്തോളം നേരത്തെ കണ്ടെത്താനാകുന്നു എന്നതിനുമുണ്ട്. പലപ്പോഴും നേരത്തെ തിരിച്ചറിയാൻ സാധിക്കുന്നില്ല എന്നതാണ് ലുക്കീമിയ അഥവാ രക്താർബുദത്തിനെ മാരകമാക്കുന്നത്. ശരീരം നൽകുന്ന ചെറിയ ചില മുന്നറിയിപ്പുകളെ അവഗണിക്കാതിരുന്നാൽ ആർക്കും രക്താർബുദം തുടക്കത്തിലേ തിരിച്ചറിയാനാകും. രക്താർബുദങ്ങൾ നേരത്തേ കണ്ടെത്തുന്നത് ചികിത്സയുടെ ഫലപ്രാപ്തി വർദ്ധിപ്പിക്കും. കൃത്യസമയത്ത് രോഗം കണ്ടെത്തുന്നത് രോഗവ്യാപനത്തെ തടയാനും രോഗമുക്തിക്കും സഹായിച്ചേക്കാം.
എന്താണ് രക്താർബുദം?
അസ്ഥി മജ്ജ ഉൾപ്പെടെയുള്ള രക്തം ഉത്പാദിപ്പിക്കുന്ന കോശങ്ങളെ ബാധിക്കുന്ന കാൻസറാണ് രക്താർബുദം. ശ്വേത രക്താണുക്കൾ അതായത് വെളുത്ത രക്താണുക്കൾ രക്തക്കുഴലുകളിലൂടെ സഞ്ചരിച്ച് പെട്ടന്ന് പെരുകുന്നതോടെ ശരീരത്തിലെ ആരോഗ്യകരമായ കോശങ്ങൾ കുറയുകയും ശരീരത്തിൽ അണുബാധക്കുള്ള സാധ്യത വർദ്ധിപ്പിക്കുകയും ചെയ്യുന്നു. വെളുത്ത രക്താണുക്കളുടെ എണ്ണം ക്രമാതീതമായി വർദ്ധിക്കുമ്പോൾ കുട്ടികളിൽ അതിവേഗം വളരുന്ന രക്താർബുദത്തിന്റെ ലക്ഷണങ്ങൾ നേരത്തെ പ്രത്യക്ഷപ്പെടാം.
രക്താർബുദത്തിന്റെ ലക്ഷണങ്ങള്
1. അമിത ക്ഷീണവും ബലഹീനതയും : ക്ഷീണം ഒരു സാധാരണ കാര്യമാണെങ്കിലും ബലഹീനതയ്ക്കൊപ്പം സ്ഥിരമായി കഠിനമായ ക്ഷീണമുണ്ടാകുന്നത് രക്താർബുദത്തിന്റെ ലക്ഷണമാകാം. ആരോഗ്യകരമായ രക്തകോശങ്ങൾ ഉൽപ്പാദിപ്പിക്കാനുള്ള ശരീരത്തിന്റെ കഴിവ് കുറയുന്നതുകൊണ്ടാണ് ഈ ലക്ഷണങ്ങൾ ഉണ്ടാകുന്നത്. ഇത് അനീമിയയിലേക്ക് നയിക്കുന്നു.
2. പെട്ടന്ന് ശരീരഭാരം കുറയുക : വ്യക്തമായ കാരണങ്ങളില്ലാതെ പെട്ടെന്ന് ശരീരഭാരം കുറയുന്നത് രക്താർബുദത്തിന്റെ പ്രാരംഭ ലക്ഷണമായിരിക്കാം. കാൻസർ കോശങ്ങൾക്ക് ശരീരത്തിന്റെ മെറ്റബോളിസത്തിൽ മാറ്റം വരുത്താനും ശരീരഭാരം കുറയ്ക്കാനും കഴിയും.
3. അടിക്കടിയുള്ള അണുബാധകൾ : രക്താർബുദം രോഗപ്രതിരോധശേഷിയെ ബാധിക്കും. ഇത് ശരീരത്തിൽ അണുബാധയുണ്ടാകാൻ കാരണമാകുന്നു. നിങ്ങൾ പതിവിലും കൂടുതൽ തവണ രോഗബാധിതനാകുന്നതായി കണ്ടെത്തിയാൽ, പ്രത്യേകിച്ച് അണുബാധകളിൽ നിന്ന് സുഖം പ്രാപിക്കാൻ കൂടുതൽ സമയമെടുക്കുകയാണെങ്കിൽ ഒരു ആരോഗ്യ വിദഗ്ധനെ സമീപിക്കണം.
4. ലിംഫ് നോഡുകൾ : ലിംഫ് നോഡുകൾ രോഗപ്രതിരോധ സംവിധാനത്തിന്റെ ഒരു പ്രധാന ഭാഗമാണ്. അവയുടെ വർദ്ധനവ് ലിംഫോമയുടെ ലക്ഷണമാകാം. ഈ വീർത്ത നോഡുകൾ സാധാരണയായി വേദനയില്ലാത്തവയായിരിക്കും. കഴുത്ത്, കക്ഷം അല്ലെങ്കിൽ ഞരമ്പ് എന്നിവടങ്ങളിൽ ഇത് കാണപ്പെടാം.
5. അസ്ഥി വേദന : രക്താർബുദം എല്ലുകളെ ബാധിക്കും. ഇത് അസ്ഥികളിൽ വേദനയുണ്ടാക്കും. സ്ഥിരമായ അസ്ഥി വേദന, പ്രത്യേകിച്ച് പുറകിലോ വാരിയെല്ലിലോ ആണെങ്കിൽ അതിനെ അവഗണിക്കാതിരിക്കുക.
ഈ ലക്ഷണങ്ങളിൽ ഏതെങ്കിലും നിങ്ങൾ ശ്രദ്ധയിൽപ്പെട്ടാൽ പരിഭ്രാന്തരാകേണ്ടതില്ല. എന്നാൽ ഉടൻ തന്നെ ഒരു ആരോഗ്യ വിദഗ്ധനെ സമീപിക്കേണ്ടത് ആവശ്യമാണ്. രക്താർബുദം നിർണ്ണയിക്കുന്നതിന് വിവിധ പരിശോധനകളും ആവശ്യമാണ്. രോഗനിർണയത്തിനായി രക്ത പരിശോധന, ബയോപ്സി, ഇമേജിംഗ്, ഫ്ലോ സൈറ്റോമെട്രി, ജനിതക പരിശോധന എന്നിവ ചെയ്യാവുന്നതാണ്.